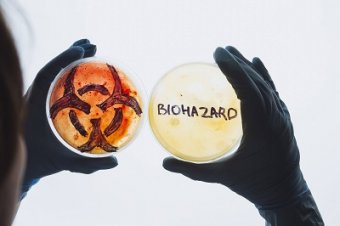
Biohazard

Jornada sobre el riesgo químico en el entorno laboral
La Subdirección General de Sanidad Ambiental y Salud Laboral del Ministerio de Sanidad, organiza una jornada sobre el riesgo químico en el entorno laboral con el lema: "Actualizando conocimiento para la prevención, visualizando retos", que tiene previsto celebrarse el próximo día 15 de junio a las 10:00 horas en el Salón de actos del Ministerio de Sanidad.
Durante la charla se tratará la legislación sobre comercialización de sustancias químicas y su repercusión en el ámbito laboral, se hablará sobre la guía técnica para la evaluación y prevención de los riesgos relacionados con los agentes químicos presentes en los lugares de trabajo y también se abordará la vigilancia de la salud de las personas con riesgo de exposición laboral a productos químicos.
En Fraternidad Muprespa trabajamos con el objetivo de reducir la siniestralidad y divulgar una adecuada cultura preventiva por eso ponemos a tu disposición en nuestro portal Previene numeroso material divulgativo con el que pretendemos ofrecer una visión general de los riesgos que pueden existir en el entorno laboral, dando recomendaciones sobre medidas preventivas que pueden aplicarse para reducir los riesgos y fomentar comportamientos seguros.